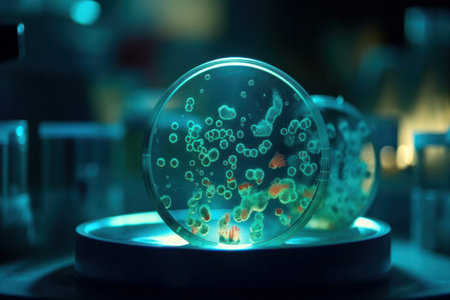
Abstract background with green bacterial growth in petri dish and pipette is AI Generative.の素材

素材 - Abstract background with green bacterial growth in petri dish and pipette is AI Generative.
作品情報
Abstract background with green bacterial growth in petri dish and pipette is AI Generative.
- ID:204477665
- 作品種別:
- 作者名:Sorapop Udomsri
キーワード
- AI
- Generative
- abstract
- antibiotic
- assay
- background
- bacteria
- beauty
- biology
- biotechnology
- blue
- bubble
- chemical
- chemistry
- clinical
- collagen
- concept
- culture
- dish
- dna
- experiment
- gel
- glass
- green
- growth
- health
- hyaluronan
- isolated
- lab
- laboratory
- liquid
- medical
- medicine
- microbiology
- natural
- oil
- organic
- petri
- pharmacy
- pipette
- research
- sample
- science
- serum
- spa
- technology
- texture
- university
- virus
- white
類似作品
St. Patrick day...
Extreme macro o...
High-resolution...
COVID-19 viral ...
Green bacteria ...
cells blue gree...
Abstract circ...
Cosmetic beauty...
Beautiful abstr...
Abstract fruit ...
In a battle wit...
abstract water ...
Cosmetic transp...
green old looki...
High-res image ...
Extreme macro o...
green glowing j...
Close-up of an ...
Texture, patter...
Paint flow. Liq...
water algae pon...
virus cells tex...
Coronavirus or ...
Detailed abstra...
Colorful flying...
A microscopic c...
Digital image o...
Virus bacteria ...
Abstract Aqua M...
Illustration of...
Abstract shapes...
A close-up of a...
Air bubbles in ...
backgrouds made...
Texture, patter...
Abstract green ...
Beautiful abstr...
Abstract glow p...
St. Patrick day...
abstract backgr...
Abstract green ...
Selective focus...
picture of a ra...